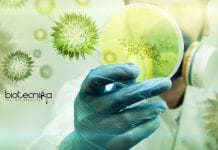
ICAR-NIVEDI Biotech & Life Science SRF Job – Online Interview ICAR-NIVEDI Biotech

Biotecnika Times – Newsletter 13.07.2020 – Newton Bhabha PhD Placement, Govt CCRAS-NARIP
Biotecnika Times - Newton Bhabha PhD Placement, Govt CCRAS-NARIP
Govt CCRAS-NARIP Recruitment 2020 – Ministry of AYUSH SRF Job
Govt CCRAS-NARIP Recruitment 2020 – Ministry of...
WHO Release New Guidelines On COVID-19 Airborne Transmission
After a few reports came out regarding the airborne transmission of the novel coronavirus, the World Health Organization has released new guidelines on Tuesday...
ICAR-IARI Research Project Recruitment – Online Interview Process
ICAR-IARI Research Project Recruitment - Online Interview Process
ICAR-IARI Research Project Recruitment - Online Interview Process. MSc/PHD Biotechnology / Life Science Jobs. MSc/PhD Biotechnology /...
ICAR-NIVEDI Biotech & Life Science SRF Job – Online Interview
ICAR-NIVEDI Biotech & Life Science SRF Job - Online Interview
ICAR-NIVEDI Biotech & Life Science SRF Job - Online Interview. NIVEDI is hiring MSc/PhD Life...
ICMR-NARI Life Sciences Technical Officer Job – Apply Online
ICMR-NARI Life Sciences Technical Officer Job - Apply Online
ICMR-NARI Life Sciences Technical Officer Job - Apply Online. National AIDS Research Institute is hiring bsc...
VIT Vellore Freshers Biochem & Biotech Research Fellow Job
VIT Vellore Freshers Biochem & Biotech Research Fellow Job
VIT Vellore Freshers Biochem & Biotech Research Fellow Job. MSc Candidates with a background in Biotechnology/Biochemistry...
Banaras Hindu University Plant Breeding and Genetics Research Job
Banaras Hindu University Genetics & Plant Breeding Research Job
Banaras Hindu University Genetics & Plant Breeding Research Job. BHU, Varanasi is hiring for research position....
China Warns Spread of An ‘Unknown Pneumonia’ Deadlier Than COVID-19
Unknown pneumonia in Kazakhstan - Chinese Embassy Warns Citizens.
A warning about unknown pneumonia has been issued by the Chinese embassy in Kazakhstan, which says...
Amity University Institute of Public Health JRF Job Opening
Amity University JRF Latest Job Opening for Biological & Life Sciences
Amity University JRF Latest Job Opening for Biological & Life Sciences. Amity Institute of...
CSIR NET Kickstarter FREE Webinar Alert – Registrations Open
CSIR NET Kickstarter Webinar
FREE Webinar Alert
How To Kickstart CSIR NET Exam Preparation?
Dear CSIR NET Aspirants & Future Researchers of India,
Mark your calendars and set...
Pfizer Life Sciences Coordinator Job – Apply Online
Pfizer Life Sciences Coordinator Job - Apply Online
Pfizer Life Sciences Coordinator Job - Apply Online. Pfizer is hiring BSc Life Sciences candidates for Reporter...
MIT Study – India Could See 2.87 Lakh COVID-19 Cases Per Day By Feb...
2.87 lakh COVID-19 cases in India every day by February 2021: MIT scientists
More than 700,000 COVID19 cases have been witnessed by India and stand...
ICMR-NICPR Biotech & Life Sciences Research Job With Rs. 43,400 pm Pay
ICMR-NICPR Biotech & Life Sciences Research Job With Rs. 43,400 pm Pay
ICMR-NICPR Biotech & Life Sciences Research Job With Rs. 43,400 pm Pay. MSc...
Gilead Starts Early-Stage Testing of Inhalable Version Of Remdesivir To Fight COVID-19
Gilead's Inhalable Form Of Remdesivir
Gilead starts early-stage testing of an inhalable form of remdesivir.
Coronavirus Drug that can be Inhaled: The American biopharmaceutical company, Gilead...
DNA Inherited From Neanderthals Linked To Increased COVID-19 Risk
DNA linked to COVID-19 was inherited from Neanderthals
According to a new research study, a stretch of DNA linked to COVID-19 was passed 60,000 years...